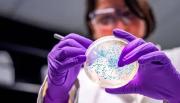
Los casos de salmonelosis cayeron con fuerza en Salta y marcan un segundo año de descenso sostenido

Sociedad
22 de enero de 2026 Página 38
Sociedad
Anses: quiénes cobran hoy jueves 22 de enero

Este jueves 22 de enero, la Administración Nacional de la Seguridad Social (Anses) continúa con el cronograma de pagos correspondiente al mes en curso y suma nuevas acreditaciones para distintos grupos de beneficiarios. La jornada combina cobros organizados por terminación... + más
Gobierno declara emergencia agrícola en Ñuble por incendios forestales

Ante la emergencia por los incendios forestales que afectan la zona sur, el Ministerio de Agricultura anunció este miércoles la declaración de emergencia agrícola para toda la Región del Ñuble. La medida, oficializada durante un despliegue en terreno en la comuna de... + más
Incendios forestales en el Ñuble y el Biobío: lo último que se sabe | La Tercera
Grupos venezolanos en Estados Unidos demandarán a Nicolás Maduro como el presunto jefe del Cartel de los Soles
Asociaciones venezolanas en el exilio anunciaron este miércoles en Miami que presentarán una querella contra Nicolás Maduro como jefe del Cartel de los Soles, asegurando que la Administración Trump retiró esos cargos en el marco de una negociación con el depuesto... + más
Mar del Plata: en 2025 subió más de un 40% la mortalidad por accidentes de tránsito

Provincia de Buenos Aires Mar del Plata: en 2025 subió más de un 40% la mortalidad por accidentes de tránsito La ONG Familiares de Víctimas del Delito y del Tránsito confirmó que los accidentes de tránsito en la ciudad marplatense aumentaron considerablemente. Las... + más
No es Reta: la localidad con playas vírgenes a cinco horas de CABA

Turismo El rincón escondido de la Costa bonaerense: a cinco horas de CABA, playas vírgenes y relax Perteneciente al partido de Lobería y con una población de apenas 20 habitantes, posee una extensión de 170 hectáreas que le valió ser declarado “Paisaje Protegido de... + más
Cuál es el error en tu CV que arruina tus entrevistas de trabajo, según expertos

Trabajo Cuál es el error en tu CV que arruina tus entrevistas de trabajo, según expertos Con la inteligencia artificial, hay grandes errores que se cometen al enviar CVs y postularse para un puesto. Lo que necesitás saber. 22 de enero, 2026 09.41 Cuál es el error en tu CV... + más
Sufrió un violento ataque, se mudó al bosque y hace 40 años no tiene agua ni luz: Es agradable
En las Tierras Altas de Escocia, a orillas del Lago Treig, un hombre vive desde hace más de 40 años de manera autosuficiente en una cabaña de troncos que construyó el mismo. Aislado por completo de la sociedad, tomó esa decisión luego de sufrir un violento ataque que... + más
Se negó a ir a un after office con sus jefes, lo despidieron y la justicia ordenó indemnizarlo con 500 mil euros
Un trabajador en Francia fue despedido luego de negarse a participar en actividades recreativas organizadas por su empresa, como fiestas, reuniones informales y after office fuera del horario laboral. La decisión derivó en un conflicto judicial que terminó con un fallo... + más
Cuánto gana Santiago del Moro por conducir Gran Hermano

La cuenta regresiva para el regreso de Gran Hermano ya comenzó. Con los últimos detalles en marcha para poner a tono la nueva casa de la Generación Dorada, Santiago del Moro se prepara para estar al frente de uno de los programas más visto de la televisión argentina. La... + más
“A todos los que me preguntan: Santiago del Moro habló sobre su salida de Telefe y se mostró indignado | Ciudad Magazine
Se salteó a Marley: se destapó lo que sucede entre el conductor y Santiago del Moro | El Intransigente
¿Fue un tsunami? Esto es lo que dice la ciencia sobre lo que pasó en la costa
El episodio que se dio hace poco en varias playas bonaerenses, donde una ola gigante llegó a la costa dejando varios heridos y un muerto generó temor. Las imágenes del agua arrasando todo llevaron a pensar en un evento extremo de origen sísmico. El contenido al que quiere... + más
Alerta de tsunami por un terremoto de magnitud 7,6 que golpeó a Japón | LMNeuquen
Un satélite de la NASA detectó desde el espacio el tsunami que generó el terremoto de Kamchatka | Ámbito
Los casos de salmonelosis cayeron con fuerza en Salta y marcan un segundo año de descenso sostenido
Durante años, la salmonelosis fue una de las enfermedades transmitidas por alimentos con mayor presencia en los reportes sanitarios de Salta. El escenario comenzó a cambiar de manera vertiginosa. Los datos oficiales correspondientes a 2025 muestran una reducción del 90% en... + más
Salta tendrá una gran cita de hockey con mil jugadoras | El Tribuno
Multas de hasta $34 mil: este es el objeto clave que debes tener en el auto para evitar una sanción económica
En Chile, todos los conductores deben seguir rigurosamente lo que establece la Ley de Tránsito. De lo contrario, autoridades pueden cursar infracciones que, además de manchar la hoja de vida de los automovilistas, implican una sanción económica. Dicha normativa señala que... + más
Estos son los cuatro documentos del auto que debes llevar SÍ o SÍ para evitar multas | Teletrece
Horóscopo hoy, domingo 21 de diciembre: revisa cómo estará el amor, dinero y salud para tu signo | La Cuarta
Deshidratación en verano: 7 tips clave para cuidarse del calor extremo

El verano trae días largos, altas temperaturas y más actividades al aire libre, pero también aumenta el riesgo de deshidratación. Muchas personas no notan que están perdiendo más líquidos de lo habitual, lo que puede afectar el rendimiento físico, el ánimo y la salud... + más
Minsal se adelanta al verano: refuerza urgencias y activa campaña frente a riesgos por calor extremo | La Tercera
Comienza el pago de la pensión de febrero: $0,37 a BCV
El gobierno nacional comenzó este jueves 22 de enero el pago de la pensión de febrero a los pensionados del Instituto Venezolano de los Seguros Sociales (Ivss). El Canal Patria Digital informó que la banca pública y privada inició la acreditación de la pensión de 130... + más
BCV ha vendido 2.480 millones de dólares a la banca por intervención cambiaria durante 2025 – Correo del Caroní | Correo del Caroní
BCV ajustó tasas de interés de la cartera de créditos y mantiene la indexación cambiaria de su valor: Gaceta Oficial | Noticia al Día
Colesterol: los seis alimentos que ayudan a prevenirlo y en qué cantidades hay que consumirlos
“Cazan una enzima, la aplastan y no se fabrica tanto colesterol”. Así describió el cardiólogo Jorge Tartaglione en su paso por LN+ al trabajo de las estatinas, un medicamento que contribuye a regular los niveles de colesterol y reduce el riesgo de infarto, ACV y... + más
¿Por el calentamiento global? Registran un marcado cambio en la conducta de los pingüinos
MADRID.- Cada año, los pingüinos regresan antes a los lugares donde ponen sus huevos y sacan adelante a sus crías. No es un fenómeno limitado a una única colonia, lo han visto en decenas de ellas y de tres especies distintas. De media, se han adelantado dos semanas, pero en... + más
Fonasa activa atención gratuita para damnificados de los incendios forestales

En respuesta a la emergencia provocada por los incendios forestales que azotan la zona centro-sur del país, el Ministerio de Salud y Fonasa anunciaron este miercoles la activación del Sistema de Atención de Fonasa para Emergencias y Desastres (SAFED). Esta medida busca... + más
Nueva y última posibilidad de licitar la MCC de Fonasa vuelve a generar cientos de dudas en aseguradoras interesadas | La Tercera
Damnificados por incendios podrán atenderse gratis en clínicas privadas mediante convenio Fonasa | El Mostrador
La titular del FMI se vio con Caputo y elogió la “fuerte performance” de la economía argentina

La jefe del FMI, Kristalina Georgieva, destacó hoy la “fuerte performance de la economía argentina” y ponderó el “progreso en la acumulación de reservas”, tras un breve encuentro con el ministro de Economía, Luis Caputo en el marco de Foro de Davos. Ambos... + más
Elecciones en Gimnasia: uno por uno, todos los nombres de las 4 listas que se oficializaron | El Día
Así quedaron definidas las listas de Gimnasia tras las correcciones | Infocielo
Catástrofe en Ñuble y Biobío reactiva urgencia por una Ley de Incendios en Chile

La catástrofe generada por los incendios que golpean a las regiones de Ñuble y Biobío nos muestran, de manera dolorosa, que aún el país está en deuda respecto a contar con herramientas más efectivas y modernas para prevenir y también mitigar el impacto de estos... + más
Incendios forestales en el Ñuble y el Biobío: lo último que se sabe | La Tercera
Incendios forestales en Ñuble y Biobío dejan más 20 mil hectáreas afectadas y alrededor de mil personas en albergues | La Tercera
VTV: los autos que no van a necesitar hacer la verificación vehicular

La Verificación Técnica Vehicular (VTV) es un control obligatorio que asegura que los vehículos circulen en condiciones seguras, luego de una minuciosa inspección. Este trámite se realiza en plantas autorizadas y tiene como objetivo prevenir accidentes y mejorar la... + más
VTV: la multa que recibirán aquellos que no tengan la verificación hecha | minutouno
Comenzaron a distribuir la vacuna contra el dengue a 11 provincias

El Ministerio de Salud de la Nación inició la distribución de 170 mil dosis de la vacuna contra el dengue a 11 provincias que están en las zonas de mayor riesgo de contagio por la presencia del mosquito transmisor de esta infección. Las dosis permitirán completar 85 mil... + más
Cinco días de cultura y gastronomía: llega el 37º Encuentro de Colectividades a Alta Gracia

Alta Gracia se prepara para vivir una nueva edición de su fiesta más emblemática. Del 4 al 8 de febrero, la ciudad del Tajamar será sede del 37º Encuentro Anual de Colectividades, un evento que convoca a vecinos y turistas de todo el país y que se consolida como uno de los... + más
“Le pegué con el cinturón a mi hijo. Lo dijo en el colegio. Ahora me llegó una citación”: Abogado se hace viral con respuesta a cruda pregunta
No es primera vez que la oficina Silard&Lara Abogados, expertos en Defensa Penal, Familia y Derecho Laboral, se hacen viral, por responder preguntas de sus seguidores. Esta vez fue una sobre una agresión a un niño.“Le pegué con el cinturón a mi hijo. Lo dijo en el colegio.... + más
PAES 2026: El ranking de la Región de Valparaíso ¿Cómo le fue a tu colegio? | El Martutino
Solidez formativa: Colegio Cruz del Sur destacó en resultados en PAES | El Pingüino
Más de 40 medidas económicas y una reforma tributaria forman el plan del futuro ministro de Hacienda de Kast

Con un escenario económico exigente por delante, el equipo económico que llegará a La Moneda en marzo ya adelantó su hoja de ruta. En un seminario de Clapes UC, el futuro ministro de Hacienda, Jorge Quiroz, expuso un plan centrado en facilitación regulatoria, rebaja... + más
Así votaron las comunas de la Región de Valparaíso en la segunda vuelta entre Kast y Jara | El Martutino
Kast presentó a Quiroz como su futuro ministro de Hacienda y se diluye opción de ingreso de Daza al gabinete | La Tercera
Notibol. Desde 2006. Central de Noticias.
Notibol es un agregador informático de noticias y no es responsable del contenido de los enlaces a los sitios externos que generan las noticias.
Acerca de Notibol | Contacto | Política de Privacidad | Descargo de Responsabilidad











